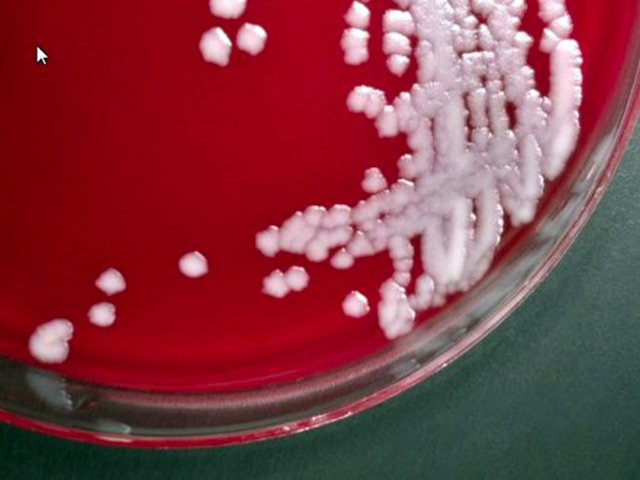

Пентагон: споры сибирской язвы разослали более чем в 50 лабораторий
Минобороны США в ночь на четверг сообщило, что живые споры сибирской язвы, об ошибочной рассылке которых стало известно в конце мая, попали в 51 лабораторию в Штатах, а также за границу - в Канаду, Южную Корею и Австралию. Это значительно больше, чем Пентагон предполагал ранее, и количество вовлеченных лабораторий может еще вырасти, передает Reuters.
Сибирскую язву разослали из военной лаборатории при полигоне Дагуэй в штате Юта. На нем проводят учения по защите от химического и биологического оружия. По сообщению Пентагона, споры должны были рассылаться в неактивном виде и затем использоваться в исследованиях, целью которых является создание полевого теста на определение безопасности окружающей среды.
В настоящее время расследование продолжается, в центре внимания вопросы контроля качества. Есть подозрение, что утечка могла длиться годами: не исключено, что стандартные процедуры по инактивации спор сибирской язвы в лаборатории в Юте были несовершенны и полученная в результате культура оставалась живой.
В Пентагоне подчеркивают, что опасности для общественности инцидент не представляет, а случаев заражения не зафиксировано.